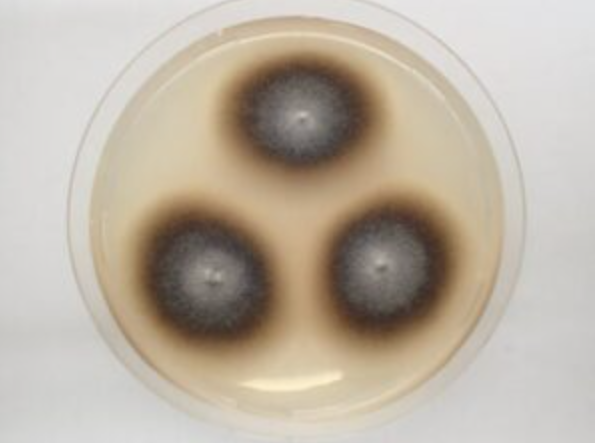

Dom bi trebao biti naše najsigurnije utočište. Ipak, u nekim slučajevima, upravo naš dom može skrivati opasnosti koje nisu odmah vidljive golim okom. Od otrovnih paukova i zmija, do toksičnih plijesni i sumnjivih pošiljki – važno je znati kako prepoznati potencijalne prijetnje i kako postupiti bez rizika.
📌 Pravilo broj 1: Ako niste sigurni – ne dirajte. Pozovite stručnjake.
🕷️ 1. Smeđi samotnjak (Loxosceles reclusa) – opasan pauk iz sjene
Mnogi pauci koje pronalazimo po kući su bezopasni, ali smeđi samotnjak je izuzetak. Iako nije agresivan, njegov ugriz može izazvati ozbiljne zdravstvene komplikacije.
📍 Gdje se skriva?
Najčešće ga nalazimo u mračnim, rijetko korištenim prostorijama – podrumima, tavanima, ormarima, iza namještaja ili među starom odjećom.
🔍 Kako ga prepoznati?
Ima karakterističnu tamnu oznaku u obliku violine na leđima. Ugrizi se dešavaju najčešće slučajno – dok se oblačimo, mijenjamo posteljinu ili pomjeramo kutije.
💬 Šta kažu stručnjaci?
Prema Centrima za kontrolu i prevenciju bolesti (CDC), reakcija na ugriz varira – od blagih simptoma, do nekroze kože i ozbiljnih infekcija.
✅ Šta učiniti ako ga vidite ili doživite ugriz:

-
❌ Ne pokušavajte ga sami ubiti ili uhvatiti.
-
📞 Pozovite stručnjake za dezinsekciju.
-
🚑 Ako vas ugrize, odmah potražite medicinsku pomoć.
🐍 2. Koraljna zmija (Micrurus spp.) – otrovna ljepotica
U toplijim krajevima poput juga SAD-a, koraljna zmija predstavlja ozbiljnu, iako rijetku prijetnju. Ova zmija je jedna od najotrovnijih u Sjevernoj Americi.
🌈 Prepoznatljiva po bojama:
Na sebi ima pruge jarko crvene, žute i crne boje. Ipak, lako se može zamijeniti s bezopasnom zmijom imitatorom – kraljevskom zmijom.
🚨 Važno upozorenje:
Nikada ne pokušavajte razlikovati zmije na licu mjesta – postoji mnogo varijacija i zabuna može biti kobna.
🧠 Savjet stručnjaka:
Prema Floridskom muzeju prirodne historije, ugrizi su rijetki, ali otrov je neurotoksičan i može izazvati paralizu, pa čak i smrt ako se ne reaguje na vrijeme.
📌 U slučaju susreta ili ugriza:
-
🚫 Ne dirajte, ne prilazite.
-
📱 Odmah kontaktirajte službu za uklanjanje divljih životinja.
-
🏥 U slučaju ugriza – pravac hitna pomoć!

☣️ 3. Crna plijesan (Stachybotrys chartarum) – skrivena prijetnja po zdravlje
Crna plijesan je vrsta toksične gljivice koja se razvija u vlažnim prostorijama – naročito nakon poplava, curenja vode ili loše ventilacije.
👃 Znakovi prisustva:
-
Tamnozeleni ili crni flekovi po zidovima i plafonima
-
Jak, ustajao miris
-
Vlažne mrlje i kondenzacija u uglovima prostorija
👨⚕️ Ko je najugroženiji?
Djeca, starije osobe, osobe s alergijama, astmom ili slabijim imunitetom posebno su osjetljive na spore plijesni koje se šire zrakom.
❗ Najveća greška:
Ne pokušavajte je sami čistiti s običnim sredstvima – to može pogoršati situaciju i proširiti spore po cijeloj kući.
🔧 Ispravan postupak:
-
☎️ Pozovite certificirane firme za uklanjanje plijesni
-
💧 Riješite izvor vlage (popravite cijevi, prozore, hidroizolaciju)
-
💨 Osigurajte dobru ventilaciju
📦 4. Sumnjivi paketi ili uređaji – prijetnja iz poštanskog sandučića
Iako vrlo rijetka pojava, povremeno se zabilježe incidenti sa nepoznatim paketima ostavljenim ispred kuće ili u poštanskom sandučiću.
🕵️♂️ Kako ih prepoznati?
-
Nema povratne adrese
-
Previše poštanskih markica
-
Sumnjivi mirisi, mrlje ili čudan zvuk iznutra
📣 Upozorenje poštanske inspekcije SAD (USPIS):
Većina neidentifikovanih paketa nije opasna, ali uvijek je bolje biti oprezan – nikada ne pretpostavljajte da je bezopasno!
🛑 Šta raditi u tom slučaju:
-
❌ Ne otvarajte, ne pomjerajte
-
🚶♂️ Uklonite se iz blizine i upozorite ukućane
-
📞 Pozovite lokalnu policiju ili poštansku inspekciju
🧯 ZAŠTO OPREZ IMA SMISLA?
U većini slučajeva, ove prijetnje su rijetke – ali kada se dogode, mogu imati ozbiljne posljedice. Uzimanje stvari u svoje ruke može:
-
😨 Pogoršati problem
-
🧪 Izložiti vas toksinima, ugrizima ili alergenima
-
⏱️ Usporiti dolazak stručne pomoći
📌 Pravilo je jednostavno:
Ostani smiren, povuci se i pozovi pomoć.
📢 NE DIRAJ – POZOVI STRUČNJAKE
Bilo da je u pitanju opasan pauk, neobična zmija, neidentifikovana plijesan ili misteriozni paket – ne igraj se detektiva. Sigurnost uvijek treba biti prioritet.
Kada znaš šta možeš prepoznati – znaš i kada da se skloniš i zaštitiš sebe i svoje najmilije. 🛡️


13 thoughts on “OPREZ U VLASTITOM DOMU: 4 TIHE PRIJETNJE KOJE TREBA IZBJEGAVATI”
Comments are closed.